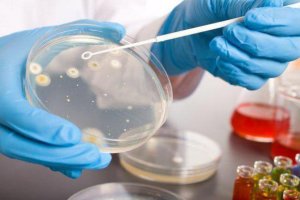
image

Уреаплазма относится к условно-патогенной микрофлоре, то есть к таким представителям микроскопического мира, которые в небольших количествах могут присутствовать в организме человека, не становясь причиной заболевания. Однако, если в организме случается сбой, и рост количества уреаплазмы в мочеполовой системе резко увеличивается, то возникает заболевание, которое называется уреаплазмоз.
Игнорировать его появление нельзя, так как передается он половым путем, следовательно, относится к ЗППП. Лечение уреаплазмоза нужно начинать как можно раньше, причем у обоих партнеров, так как при половых контактах будет происходить перезаражение и заболевание примет хроническую, трудноизлечимую форму.
Причины и симптомы
Уреаплазмоз – это ИППП, которую вызывают микроорганизмы (уреаплазмы)
Уреаплазма уреалитикум у мужчин встречается реже, чем у женщин, и не так часто приводит к появлению серьезного воспалительного процесса в мочеполовой системе. Так как чаще всего источником заражения служит женщина, в мужской организм может попадать немного возбудителей, и они успешно подавляются работой иммунной системы человека. Но если иммунитет ослаблен, то уреаплазмы могут начать стремительно размножаться. В этой ситуации возникает воспалительное заболевание, которое носит название уреаплазменной инфекции.
В отличие от представительниц прекрасного пола, у которых заражение уреаплазмой может проходить бессимптомно, у мужчин в силу специфики строения мочеполовых органов, заболевание обычно проходит бурно и имеет выраженные симптомы.
После попадания в организм этих микроорганизмов мужчина страдает от следующих симптомов:
- Жжение, зуд и сильный дискомфорт.
- Болезненность и резь при мочеиспускании.
- Прозрачные, водянистые или слизистые выделения.
Уреаплазмоз не проявляется сразу после инфицирования. В среднем инкубационный период заболевания составляет от 14 дней до нескольких месяцев, поэтому быстро поставить диагноз достаточно сложно.
Кроме того, уреаплазмы могут эффективно угнетаться собственной иммунной системой мужчины, поэтому заболевание может находиться в «спящем» режиме и проявляться только при падении иммунитета, например, после сильного стресса, простуды или появления какой-то другой болезни. Кроме того, так как заболевание передается половым путем, оно может сопровождаться другими ЗППП, яркие проявления которых могут «замаскировать» наличие уреаплазмы.
Уреаплазмоз провоцирует появление множества осложнений, который могут быть причинами развития серьезных болезней.
Чаще всего причиной посещения кабинета уролога становятся жалобы на проявления уретрита, то есть на возникновение жжения и рези в мочеиспускательном канале, которые резко усиливаются при отделении мочи. При запущенном состоянии могут появиться признаки простатита с тянущими болями в промежности и нарушениями половой функции, а также воспаление придатков яичка — эпидидимит.
Диагностика
Бак посев на уреаплазму уреалитикум
Так как уреаплазма уреалитикум у мужчин протекает достаточно бурно, то обращение к медикам обычно происходит с появлением острых симптомов. Для того, чтобы точно установить диагноз и исключить наличие сопутствующих заболеваний, передающихся при половых контактов, врач обычно назначает прохождение целого ряда анализов и обследований.
В них обычно входят следующие (не обязательно все полностью):
- Бактериологический посев мазка на предмет обнаружения уреаплазмы и присутствия возможных других микроорганизмов.
- Проба на ПЦР, если бак посев не дал точного результата.
- Иммуноферментный анализ, или ИФА.
- Прямая иммунофлюоресценция, или ПИФ.
- Спермограмма (если выявлены или есть подозрения на наличие патологий системы воспроизводства, заболевания простаты и другие болезни половой сферы мужчины).
- Исследование эякулята на микробиологию.
Если уреаплазма или другие возбудители будут выявлены, а у мужчины имеются жалобы или явные признаки других заболеваний мочеполовой системы, список анализов и обследований может быть расширен по требованию и назначению врача.
Методика лечения
Эффективное и правильно лечение уреаплазмоза может назначить только врач
Лечение уреаплазма уреалитикум у мужчин проводится комплексно, длится от 14 дней и более, в зависимости от тяжести и степени запущенности заболевания, а также от наличия отягощающих факторов: дополнительной инфекции или сопутствующих заболеваний.
В этом случае срок лечения может быть продлен на необходимый срок до достижения стойкого результата и полного освобождения организма от возбудителей. Препараты и способы лечения всегда подбираются врачом индивидуально, так как реакции каждого организма непредсказуемы, а «букет» инфекций у каждого больного может быть собственный.
В основном для лечения применяются следующие препараты:
- Антибиотики (строго по предписанию врача).
- Противогрибковые, противовирусные и другие специфические лекарства, направленные на угнетение сопутствующей патогенной микрофлоры.
- Введение в уретру специальных препаратов от уреаплазмы и других возбудителей.
- Физиотерапевтические процедуры.
- Иммуномодуляторы и общеукрепляющие препараты для усиления и поддержания работы собственного иммунитета пациента.
- Витаминно-минеральные комплексы.
При лечении нельзя произвольно менять препараты, отказываться от них, увеличивать или уменьшать дозировку, а также прерывать процесс лечения. Невылеченный полностью уреаплазмоз переходит в хроническую форму, при которой может не проявляться внешне, но продолжать разрушать организм изнутри.
Возможные осложнения
Запущенный уреаплазмоз может спровоцировать развитие более серьезных осложнений
При своевременном и правильно проведенном лечении уреаплазма уреалитикум у мужчин осложнений обычно удается избежать. Если же этого не сделать, или не довести процесс до конца, то это может привести к превращению острого заболевания в хроническое.
В результате могут появиться следующие осложнения:
- Простатит.
- Эпидидимит.
- Уретрит.
- Снижение продуктивности и активности спермы.
- Бесплодие.
- Мочекаменная болезнь.
- Сужение мочеиспускательного канала.
- Артрит.
- Психологический дискомфорт и проблемы в интимной жизни.
Это неполный перечень того, чем может осложниться уреаплазмоз без лечения, на деле неприятных последствий может быть намного больше.
Лучшее средство избежать заражения — это защищенные половые контакты. Через презерватив уреаплазма не проникает, то барьерные методы контрацепции — это наиболее эффективный способ защиты от заболевания. Безусловно, беспорядочный секс очень опасен, и уреаплазмоз — это еще самая малость из того огромного количества заболеваний, которые он с собой может принести.
Больше информации об уреаплазмозе можно узнать из видео:
Если после незащищенного полового акта появляются любые неприятные симптомы, нужно немедленно обращаться к медикам. Своевременное лечение спасет от распространения инфекции и не позволит появиться осложнениям, кроме того, успешно пролечившийся мужчина перестает быть источником заражения для женщины. При появлении признаков заражения у мужчины идти на обследование обязательно должны оба партнера, даже если у женщины никаких симптомов не наблюдается. Особенности анатомии женского тела могут сглаживать симптомы болезни, тогда как у мужчины они сразу становятся заметными. Лечится также должны оба, естественно, избегая при этом незащищенных половых контактов. Только в этом случае можно рассчитывать на полное выздоровление.
Опытные медики рекомендуют через какое-то время после успешно пройденного курса лечения (через месяц или два) вновь сдать анализы на уреаплазму (тоже вдвоем), чтобы окончательно убедиться в полном исчезновении источников инфекции. В противном случае весь курс придется заново повторить.
Заметили ошибку? Выделите ее и нажмите Ctrl+Enter, чтобы сообщить нам.